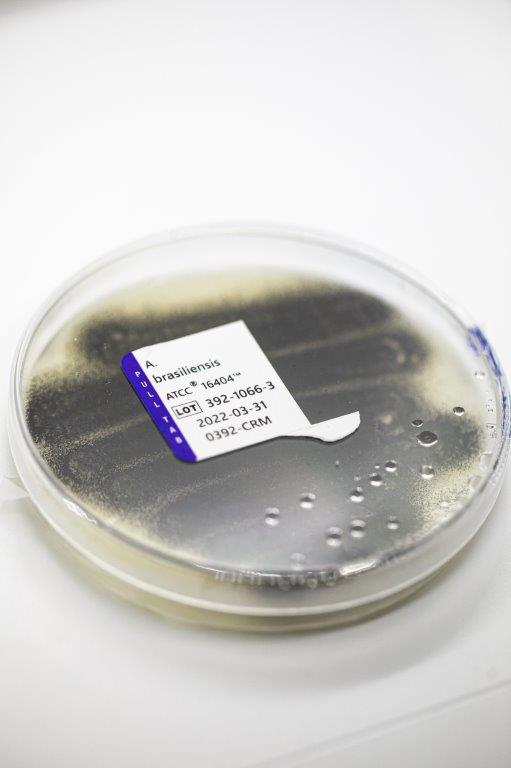
Laboratório de Microbiologia

O Laboratório realiza análises microbiológicas em diversas matrizes, incluindo águas, alimentos, ar ambiente, cosméticos, medicamentos e efluentes líquidos.
Também são conduzidos controles microbiológicos em fossas nasais e unhas de trabalhadores que atuam em áreas críticas dos setores de saúde e de alimentos, contribuindo para a prevenção de contaminações e a garantia da segurança sanitária.
Além disso, o laboratório executa estudos de estabilidade, em conformidade com a legislação vigente, assegurando a qualidade e a durabilidade dos produtos ao longo do tempo.
As análises contemplam a avaliação qualitativa e quantitativa de microrganismos, incluindo bactérias, fungos e leveduras, tanto patogênicos quanto não patogênicos. No contexto microbiológico, também são realizadas determinações de micotoxinas e aflatoxinas.
O setor atua de forma integrada, complementando as atividades dos laboratórios de Águas, Higiene Ocupacional, Química e Toxicologia, oferecendo suporte técnico especializado.